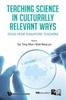
Книга Teaching Science In Culturally Relevant Ways: Ideas From Singapore Teachers

Сайт не поддерживает ваш браузер. Пожалуйста, обновите браузер, или скачайте другой
Продолжая использовать joom.ru, вы подтверждаете, что согласны с Правилами использования и Политикой конфиденциальности, в том числе, с порядком использования cookie-файлов.
Книга Singapore???s Approach To Developing Teachers : Hindsight, Insight, and Foresight
Текущая цена
Цена 9 990 ₽ руб.
Бесплатная доставка 5-10 февраля
Условия возврата
Надежные платежи




Поддержка говорит по-русски
Описание
Похожие товары